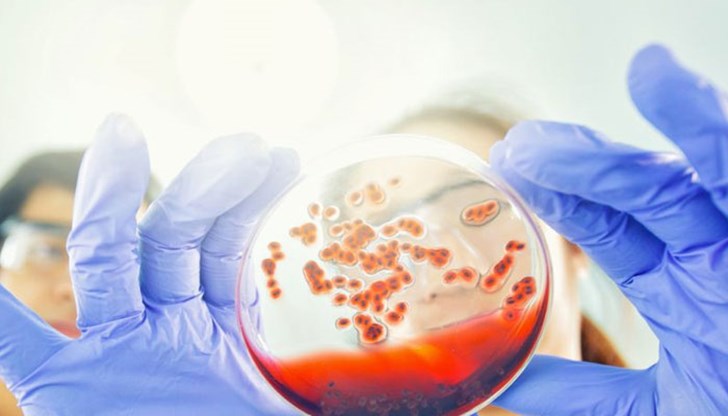
Това наблюдение е първата стъпка и за пръв път, доколкото ми е известно, че ХИВ е лечимо заболяване, коментира един от водещите автори на изследването Това наблюдение е първата стъпка и за пръв път, доколкото ми е известно, че ХИВ е лечимо заболяване, коментира един от водещите автори на изследването

За първи път унищожиха ХИВ в геном на живо същество
- Редактор: Петя Георгиева
- Коментари: 0
Няма съмнение, че мощните анти-ХИВ лекарства могат да свършат доста добра работа, за да поддържат вируса под контрол. Използвани правилно, тези антиретровирусни лекарства (ARV) могат да потиснат ХИВ достатъчно, за да го поддържат на нива толкова ниски, че да бъдат неоткриваеми в кръвта, което драстично намалява шанса за разпространение на вируса по време на сексуална активност или трансфузии. Но ARV могат да направят само толкова, пише "Тайм", предава News.bg.
Те работят най-добре върху вируси, които активно правят копия от себе си и заразяват здрави клетки. ХИВ е еволюирал, "учи" това и може да мутира, за да стане резистентен към лекарствата, така че веднага щом атаката на лекарството спре, вирусите се репликират. ХИВ също може да се запази, като се скрие, спре и не се размножава в лимфата и други тъкани в цялото тяло. Когато имунната система се откаже, тези латентни вируси могат да започнат да се размножават отново. Всичко това означава, че след като човек е заразен, тези вируси остават в организма и просто е чакат да се затрупа имунната система с милиони инфекциозни вируси, години или дори десетилетия, след като ХИВ заразява първата клетка.
Намирането и премахването на всяка следа от вируса би било много по-добро решение от ARV. Но засега изследователите не са успели да създадат ваксина или нещо, което може да направи това.
В проучване, публикувано в Nature Communications, учени съобщават за възможен нов начин за елиминиране на ХИВ от генома на заразено живо същество. В проучване, включващо 29 мишки, при някои от животните екипът използва комбинация от модифицирано лечение с ARV, за да поддържа вируса при ниски нива на активност, заедно с мощна техника за редактиране на ген, която откъсва вируса на ХИВ от заразени клетки. При различни тестове учените не са могли да намерят следа от вируса при 30% от животните.
"Това наблюдение е първата стъпка и за пръв път, доколкото ми е известно, че ХИВ е лечимо заболяване", коментира един от водещите автори на изследването Камел Халили, директор на Центъра за невровирология и на Комплексния център за невроСПИН в университета Темпъл.
Първо, изследователите намаляват активно репликирането на вируса в кръвта, използвайки конвенционални ARV лекарства, модифицирани с процес, наречен LASER ART. Процесът е разработен от д-р Хауърд Генделман, председател на фармакологията и експерименталната невронаука в Медицинския център на Университета в Небраска, и следващ водещ автор на изследването.
С LASER ART традиционните анти-ХИВ лекарства се натрупват и развиват кристална структура и след това се заграждат в мастноразтворими частици. Това им позволява да се плъзгат през мембраните на клетките на места, където ХИВ има тенденция да се скрие, като черния дроб, лимфната тъкан и далака. Веднъж вътре, ензимите на клетките започват да отделят лекарството. Кристалната структура освобождава лекарствата по-бавно, което им позволява да продължат да убиват отпадналите вируси, тъй като те започват да се появяват и да се възпроизвеждат в продължение на месеци, а не дни или седмици, като е при конвенционалните форми на лекарствата.
Втората стъпка включва използването на инструмент за редактиране на гени CRISPR-cas9 срещу ХИВ във всички циркулиращи клетки, заразени с вирусни гени - клетки, които анти-ХИВ лекарствата са пропуснали.
Преди това Халили е използвал CRISPR, за да измъкне успешно вирусите на ХИВ от човешки клетки в лаборатория, както и от лабораторни животни. Но когато се използва самостоятелно, CRISPR не е достатъчен; след като ХИВ се репликира, той създава толкова много копия, че не е възможно CRISPR да ги редактира всички. Всъщност някои от мишките са били лекувани само с CRISPR, а някои само с LASER ART; и в двете от тези групи нивата на ХИВ се възстановяват в крайна сметка през период от пет до осем седмици.
Въпреки това, в комбинация с LASER ART, двете терапии ефективно елиминират ХИВ от животните.
"През годините ние разглеждаме ХИВ като инфекциозно заболяване. Но след като попадне в клетката, той вече не е инфекциозно заболяване, а се превръща в генетично заболяване, тъй като вирусният геном е включен в гена на гостоприемника", обяснява Халили.
"За да излекуваме болестта, се нуждаем от генетична стратегия. Редактирането на ген ни дава възможност да елиминираме вирусна ДНК от гостоприемни хромозоми, без да нараним гостоприемника."
Технологията CRISPR-cas9 е забележително точна и прецизна в тестовете върху животни, като маха само ХИВ гени, без да прави нежелани съкращения другаде в ДНК на мишките, допълва Халили.
"Изследователите също така взимат клетки на имунната система в които е имало ХИВ, от животни, лекувани както с LASER ART, така и с CRISPR и ги прехвърлят на здрави животни, за да проверят дали те са развили ХИВ инфекция от някой вирус, който може да е останал, но никое не развива".
"Доста сме уверени в резултата и сме много доволни, че при малки животни, използвайки разработената от нас технология и метод, човек може да постигне това, което наричаме стерилизиращ лек или елиминиране на вируса", обяснява Халили.
Екипът вече тества терапията при примати и се надява да потвърди същите резултати. Ако може, това ще отвори вратата за тестове на лечение при хора.























Камери ще следят трафика по ремонтирания път край Николово
Умни светофари за 500 000 евро ще регулират трафика по...
Румен Радев откри кампанията на „Прогресивна България“ в...
Умни светофари за 500 000 евро ще регулират трафика по...
Румен Радев откри кампанията на „Прогресивна България“ в...